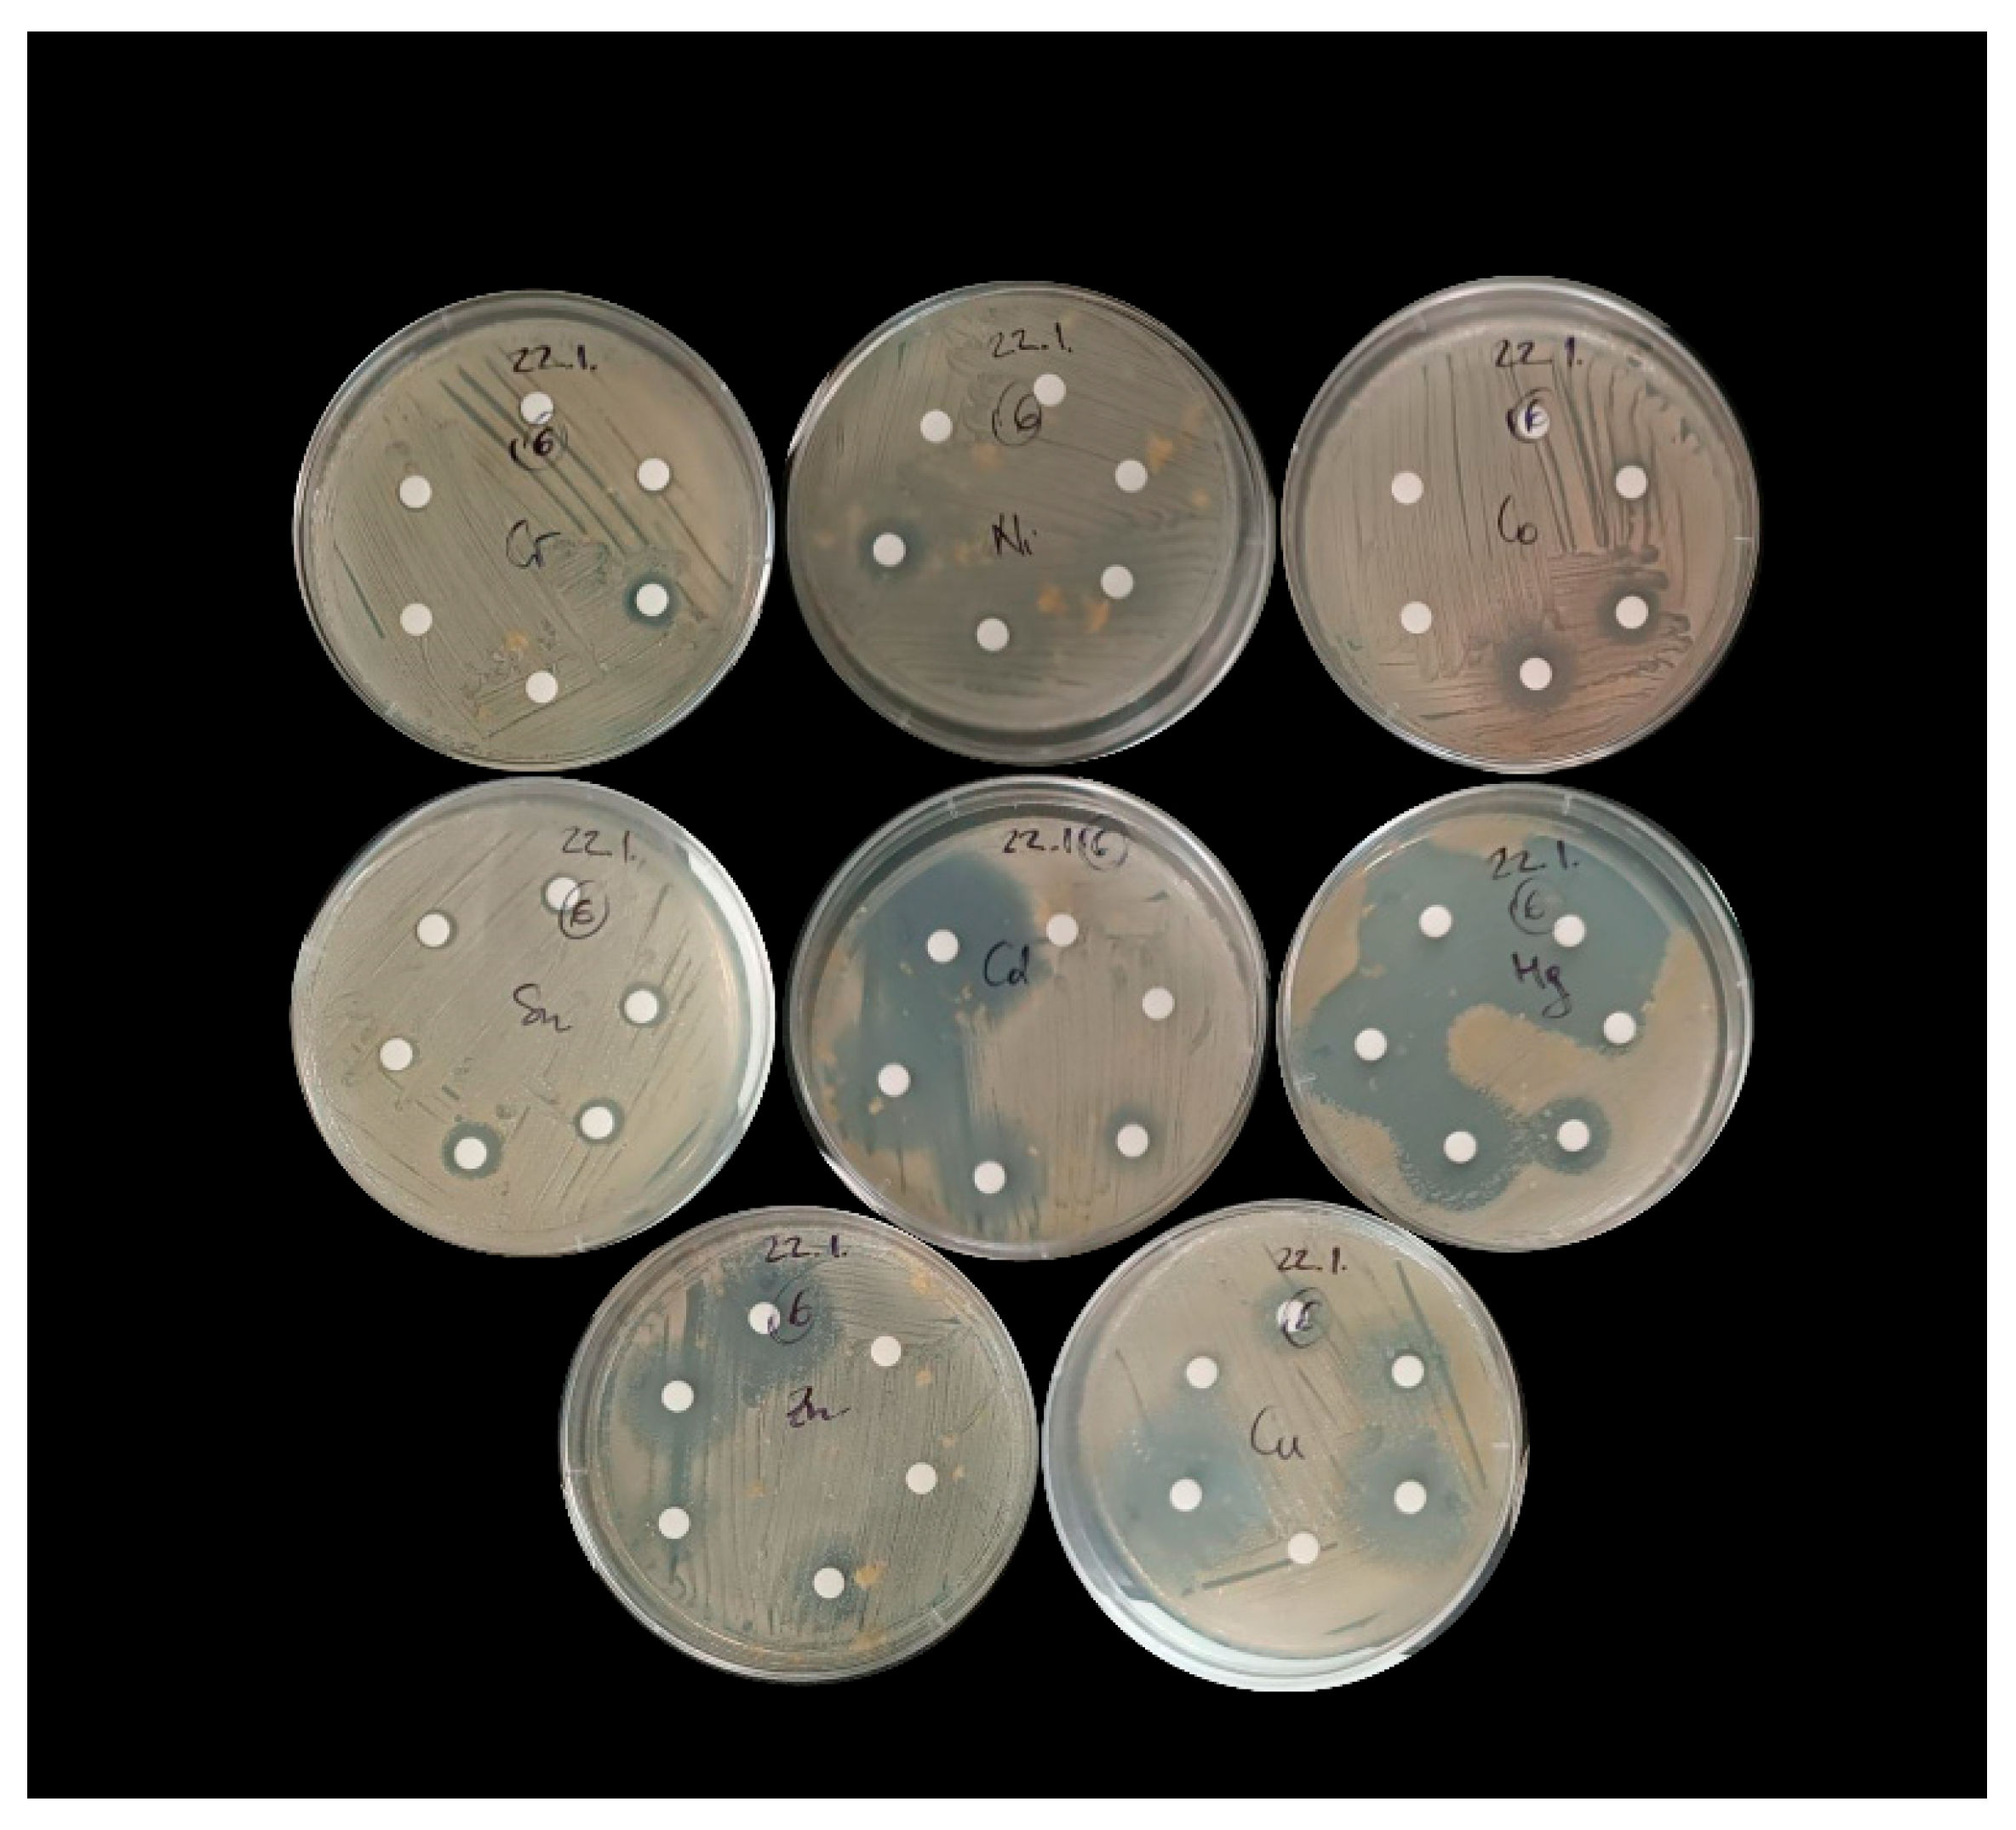
Preprints 175781 g002

Submitted:
08 September 2025
Posted:
09 September 2025
You are already at the latest version
Abstract
In this study, 74 bacterial isolates were obtained from sediments of Šibenik Bay, historically impacted by heavy-metal pollution. Isolates were tested for tolerance to cadmium (Cd), cobalt (Co) chromium (Cr), copper (Cu), mercury (Hg), nickel (Ni), lead (Pb), tin (Sn) and zinc (Zn), both individually and in mixtures, and for their biofilm-forming ability. Toxicity followed the trend Hg > Sn > Zn/Cd/Cr > Co/Ni > Pb. Resistance traits were observed against all tested metals, with some isolates displaying multi-metal resistance to as many as seven metals, reflecting long-term selective pressure in the Bay. Bacillus species dominated the community (48 isolates across five clusters), confirming this genus as the principal group in metal-polluted sediments. Several less-explored genera including Ruegeria/ Cribrihabitans, Bhargavaea, Pseudoalteromonas, and Lysinibacillus/Sporosarcina also exhibited notable resistance traits, underscoring their potential as novel candidates for bioremediation. Eleven isolates from Bacillus/Mesobacillus/Cytobacillus, Bacillus/Peribacillus/Rossellomorea, Bacillus/Pseudoalkalibacillus/ Alkalibacillus, Lysinibacillus/Sporosarcina, and Ruegeria/Cribrihabitans clusters showed resistance and robust growth under metal mixtures. Among all isolates, 11, 32, 81, 82(Bacillus/Mesobacillus/ Cytobacillus and Bacillus/Peribacillus/Rossellomorea) combined broad multi-metal tolerance with strong biofilm formation, positioning them as candidates for site-specific, nature-based bioremediation of heavy-metal impacted coastal ecosystems such as Šibenik Bay.
Keywords:
1. Introduction
2. Materials and Methods
2.1. Study Sites, Sediment Sampling, and Chemical Characterization
2.2. Isolation and Identification of Bacterial Isolates from Sediment
2.3. Testing the Resistance of Bacterial Isolates to Individual Metals Using the Disk Diffusion Method
2.4. Testing the Resistance of Bacterial Isolates to Metal Mixtures in 96-Well Plates
2.5. Assessment of Biofilm-Forming Ability of Bacterial Isolates
3. Results
3.1. Measured Levels of Metals in Sediment Samples
3.2. Phylogenetic Affiliation of Bacterial Isolates
3.3. Tolerance of Sediment Bacterial Isolates to Individual Metals
3.4. Tolerance of Sediment Bacterial Isolates to Heavy Metal Mixtures
3.5. Biofilm Forming Ability of Bacterial Isolates
4. Discussion
5. Conclusions
Supplementary Materials
Author Contributions
Funding
Institutional Review Board Statement
Informed Consent Statement
Data Availability Statement
Acknowledgments
Conflicts of Interest
References
- Tchounwou, P.B.; Yedjou, C.G.; Patlolla, A.K.; Sutton, D.J. Heavy Metal Toxicity and the Environment. In Molecular, Clinical and Environmental Toxicology; Luch, A., Ed.; Experientia Supplementum; Springer Basel: Basel, Switzerland, 2012; Volume 101, pp. 133–164. [Google Scholar]
- Wang, D.; Li, H.; Wei, Z.; Wang, X.; Hu, F. Effect of earthworms on the phytoremediation of zinc-polluted soil by ryegrass and Indian mustard. Biol. Fertil. Soils 2006, 43(1), 120–123. [Google Scholar] [CrossRef]
- Ray, S.A.; Ray, M.K. Bioremediation of heavy metal toxicity-with special reference to chromium. Al Ameen J. Med. Sci. 2009, 2, 57–63. [Google Scholar]
- Balali-Mood, M.; Naseri, K.; Tahergorabi, Z.; Khazdair, M.R.; Sadeghi, M. Toxic Mechanisms of Five Heavy Metals: Mercury, Lead, Chromium, Cadmium, and Arsenic. Front. Pharmacol. 2021, 12, 643972. [Google Scholar] [CrossRef]
- Robledo Ardila, P.A.; Álvarez-Alonso, R.; Árcega-Cabrera, F.; Durán Valsero, J.J.; Morales García, R.; Lamas-Cosío, E.; Oceguera-Vargas, I.; DelValls, A. Assessment and Review of Heavy Metals Pollution in Sediments of the Mediterranean Sea. Applied Sciences 2024, 14, 1435. [Google Scholar] [CrossRef]
- Hama Aziz, K.H.; Mustafa, F.S.; Omer, K.M.; Hama, S.; Hamarawf, R.F.; Rahman, K.O. Heavy Metal Pollution in the Aquatic Environment: Efficient and Low-Cost Removal Approaches to Eliminate Their Toxicity: A Review. RSC Adv. 2023, 13, 17595–17610. [Google Scholar] [CrossRef] [PubMed]
- El Boudammoussi, M.; El Hammoudani, Y.; Haboubi, K.; Achoukhi, I.; Moudou, M.; Faiz, H.; Touzani, A.; Dimane, F. State of the Art of Trace Metal Detection in the Mediterranean Coastal Marine Environment, Combinatorial Approach Using Mytilus Galloprovincialis and Surface Sediments. E3S Web Conf. 2024, 527, 02009. [Google Scholar] [CrossRef]
- Romano, E.; Bergamin, L.; Croudace, I.W.; Pierfranceschi, G.; Sesta, G.; Ausili, A. Measuring Anthropogenic Impacts on an Industrialised Coastal Marine Area Using Chemical and Textural Signatures in Sediments: A Case Study of Augusta Harbour (Sicily, Italy). Sci. Total Environ. 2021, 755, 142683. [Google Scholar] [CrossRef] [PubMed]
- Sodhi, K.K.; Mishra, L.C.; Singh, C.K.; Kumar, M. Perspective on the Heavy Metal Pollution and Recent Remediation Strategies. Curr. Res. Microb. Sci. 2022, 3, 100166. [Google Scholar] [CrossRef]
- Alabssawy, A.N.; Hashem, A.H. Bioremediation of Hazardous Heavy Metals by Marine Microorganisms: A Recent Review. Arch. Microbiol. 2024, 206, 103. [Google Scholar] [CrossRef]
- Abo-Alkasem, M.I.; Hassan, N.H.; Abo Elsoud, M.M. Microbial Bioremediation as a Tool for the Removal of Heavy Metals. Bull. Natl. Res. Cent. 2023, 47, 31. [Google Scholar] [CrossRef]
- Dell’Anno, A.; Beolchini, F.; Corinaldesi, C.; Amato, A.; Becci, A.; Rastelli, E.; Hekeu, M.; Regoli, F.; Astarita, E.; Greco, S.; et al. Assessing the Efficiency and Eco-Sustainability of Bioremediation Strategies for the Reclamation of Highly Contaminated Marine Sediments. Mar. Environ. Res. 2020, 162, 105101. [Google Scholar] [CrossRef] [PubMed]
- Kalkan, S. Heavy Metal Resistance of Marine Bacteria on the Sediments of the Black Sea. Mar. Pollut. Bull. 2022, 179, 113652. [Google Scholar] [CrossRef]
- Pande, V.; Pandey, S.C.; Sati, D.; Bhatt, P.; Samant, M. Microbial Interventions in Bioremediation of Heavy Metal Contaminants in Agroecosystem. Front. Microbiol. 2022, 13, 824084. [Google Scholar] [CrossRef]
- Ianeva, OD. [Mechanisms of bacteria resistance to heavy metals]. Mikrobiol Z. 2009, 71, 54–65. [Google Scholar]
- Coelho Da Costa Waite, C.; Oliveira Andrade Da Silva, G.; Pires Bitencourt, J.A.; Pereira Torres Chequer, L.; Pennafirme, S.; De Azevedo Jurelevicius, D.; Seldin, L.; Araújo Carlos Crapez, M. Potential Application of Pseudomonas Stutzeri W228 for Removal of Copper and Lead from Marine Environments. PLoS ONE 2020, 15, e0240486. [Google Scholar] [CrossRef]
- Chen, Q.; Li, Y.; Liu, M.; Zhu, B.; Mu, J.; Chen, Z. Removal of Pb and Hg from Marine Intertidal Sediment by Using Rhamnolipid Biosurfactant Produced by a Pseudomonas Aeruginosa Strain. Environ. Technol. Innov. 2021, 22, 101456. [Google Scholar] [CrossRef]
- Shi, J.; Wu, X.; Zhao, X.; Zhou, J.; Liu, S.; Li, B.; Zhang, J.; Li, W.; Zeng, X.; Wang, X.; et al. Remediation of Heavy Metal-Contaminated Estuarine Sediments by Strengthening Microbial in-Situ Mineralization. Appl. Geochem. 2024, 169, 106051. [Google Scholar] [CrossRef]
- Syed, Z.; Sogani, M.; Rajvanshi, J.; Sonu, K. Microbial Biofilms for Environmental Bioremediation of Heavy Metals: A Review. Appl Biochem Biotechnol 2023, 195, 5693–5711. [Google Scholar] [CrossRef]
- Haque, Md.M.; Mosharaf, M.K.; Haque, Md.A.; Tanvir, Md.Z.H.; Alam, Md.K. Biofilm Formation, Production of Matrix Compounds and Biosorption of Copper, Nickel and Lead by Different Bacterial Strains. Front. Microbiol. 2021, 12, 615113. [Google Scholar] [CrossRef]
- Nnaji, N.D.; Anyanwu, C.U.; Miri, T.; Onyeaka, H. Mechanisms of Heavy Metal Tolerance in Bacteria: A Review. Sustainability 2024, 16, 11124. [Google Scholar] [CrossRef]
- Jasu, A.; Ray, R.R. Biofilm Mediated Strategies to Mitigate Heavy Metal Pollution: A Critical Review in Metal Bioremediation. Biocatal. Agric. Biotechnol. 2021, 37, 102183. [Google Scholar] [CrossRef]
- Chien, C.-C.; Lin, B.-C.; Wu, C.-H. Biofilm Formation and Heavy Metal Resistance by an Environmental Pseudomonas Sp. Biochem. Eng. J. 2013, 78, 132–137. [Google Scholar]
- Majumder, A.; Bhattacharyya, K.; Kole, S.C.; Ghosh, S. Efficacy of Indigenous Soil Microbes in Arsenic Mitigation from Contaminated Alluvial Soil of India. Environ. Sci. Pollut. Res. 2013, 20, 5645–5653. [Google Scholar] [CrossRef]
- Shah, S.M.; Khan, S.; Bibi, N.; Rehman, B.; Ali, R.; Shireen, F.; Yilmaz, S.; Ali, Q.; Ullah, A.; Ali, D. Indigenous Bacteria as Potential Agents for Trace Metal Remediation in Industrial Wastewater. Sci. Rep. 2025, 15, 13141. [Google Scholar] [CrossRef]
- Cukrov, N.; Doumandji, N.; Garnier, C.; Tucaković, I.; Dang, D.H.; Omanović, D.; Cukrov, N. Anthropogenic Mercury Contamination in Sediments of Krka River Estuary (Croatia). Environ Sci. Pollut. Res. 2020, 27, 7628–7638. [Google Scholar] [CrossRef]
- Bogner, D.; Ujević, I.; Zvonarić, T.; Barić, A. Distribution of selected trace metals in coastal surface sediments from the middle and south Adriatic. Fresen. Environ. Bull. 2004, 13, 1281–1287. [Google Scholar]
- Cukrov, N.; Frančišković-Bilinski, S.; Mikac, N.; Roje, V. Natural and anthropogenic influences recorded in sediments from the Krka river estuary (eastern Adriatic coast), evaluated by statistical methods. Fresen. Environ. Bull. 2008, 17, 855–863. [Google Scholar]
- Mikac, N.; Kwokal, Z.; May, K.; Branica, M. Mercury Distribution in the Krka River Estuary (Eastern Adriatic Coast). Mar. Chem. 1989, 28, 109–126. [Google Scholar] [CrossRef]
- Mikac, N.; Kwokal, Ž.; Martinčić, D.; Branica, M. Uptake of Mercury Species by Transplanted Mussels Mytilus Galloprovincialis under Estuarine Conditions (Krka River Estuary). Sci. Total Environ. 1996, 184, 173–182. [Google Scholar] [CrossRef] [PubMed]
- Mikac, N.; Roje, V.; Cukrov, N.; Foucher, D. Mercury in aquatic sediments and soils from Croatia. Arhiv za higijenu rada i toksikologiju 2006, 57, 325. [Google Scholar]
- Cindrić, A.-M.; Garnier, C.; Oursel, B.; Pižeta, I.; Omanović, D. Evidencing the Natural and Anthropogenic Processes Controlling Trace Metals Dynamic in a Highly Stratified Estuary: The Krka River Estuary (Adriatic, Croatia). Mar. Pollut. Bull. 2015, 94, 199–216. [Google Scholar] [CrossRef]
- Huljek, L.; Strmić Palinkaš, S.; Fiket, Ž.; Fajković, H. Environmental Aspects of Historical Ferromanganese Tailings in the Šibenik Bay, Croatia. Water 2021, 13, 3123. [Google Scholar] [CrossRef]
- Ramljak, A.; Žučko, J.; Lučić, M.; Babić, I.; Morić, Z.; Fafanđel, M.; Furdek Turk, M.; Matijević, S.; Karpouzas, D.; Udiković-Kolić, N.; et al. Microbial Communities as Indicators of Marine Ecosystem Health: Insights from Coastal Sediments in the Eastern Adriatic Sea. Mar. Pollut. Bull. 2024, 205, 116649. [Google Scholar] [CrossRef]
- Sutherland, Ross. A. A Comparison of Geochemical Information Obtained from Two Fluvial Bed Sediment Fractions. Environ. Geol. 2000, 39, 330–341. [Google Scholar] [CrossRef]
- Fiket, Z.; Mikac, N.; Kniewald, G. Mass Fractions of Forty-Six Major and Trace Elements, Including Rare Earth Elements, in Sediment and Soil Reference Materials Used in Environmental Studies. Geostand. Geoanalytical Res. 2016, 14, 123–135. [Google Scholar] [CrossRef]
- Sierra, C.; Ordóñez, C.; Saavedra, A.; Gallego, J.R. Element Enrichment Factor Calculation Using Grain-Size Distribution and Functional Data Regression. Chemosphere 2015, 119, 1192–1199. [Google Scholar] [CrossRef]
- Birch, G.F.; Lee, J.-H.; Gunns, T.; Besley, C.H. The Use of Sedimentary Metals to Assess Anthropogenic Change, Ecological Risk, Model Past and Future Impacts and Identify Contaminant Sources in the Eleven Estuaries of Greater Sydney (Australia): A Review and Critical Assessment. Sci. Total Environ. 2024, 950, 175268. [Google Scholar] [CrossRef] [PubMed]
- Cukrov, N.; Frančišković-Bilinski, S.; Bogner, D. Metal Contamination Recorded in the Sediment of the Semi-Closed Bakar Bay (Croatia). Environ. Geochem. Health 2014, 36, 195–208. [Google Scholar] [CrossRef] [PubMed]
- Senko, H.; Kajić, S.; Huđ, A.; Palijan, G.; Petek, M.; Rajnović, I.; Šamec, D.; Udiković-Kolić, N.; Mešić, A.; Brkljačić, L.; et al. Will the Beneficial Properties of Plant-Growth Promoting Bacteria Be Affected by Waterlogging Predicted in the Wake of Climate Change: A Model Study. Appl. Soil Ecol. 2024, 198, 105379. [Google Scholar] [CrossRef]
- Letunic, I.; Bork, P. Interactive Tree Of Life (iTOL) v5: An Online Tool for Phylogenetic Tree Display and Annotation. Nucleic Acids Res. 2021, 49, W293–W296. [Google Scholar] [CrossRef]
- Liu, C.-H.M.; Dahms, H.-U.; Hsieh, C.-Y.; Lin, Z.-Y.; Lin, T.-Y.; Huang, X.-Q. Bacterial Heavy Metal Resistance Related to Environmental Conditions. Chemosphere 2024, 347, 140539. [Google Scholar] [CrossRef] [PubMed]
- O’Toole, G.A. Microtiter Dish Biofilm Formation Assay. JoVE 2011, 2437. [Google Scholar]
- Joshi, G.; Verma, P.; Meena, B.; Goswami, P.; Peter, D.M.; Jha, D.K.; Vinithkumar, N.V.; Dharani, G. Unraveling the Potential of Bacteria Isolated from the Equatorial Region of Indian Ocean in Mercury Detoxification. Front. Mar. Sci. 2022, 9, 986493. [Google Scholar] [CrossRef]
- Covelli, S.; Langone, L.; Acquavita, A.; Piani, R.; Emili, A. Historical Flux of Mercury Associated with Mining and Industrial Sources in the Marano and Grado Lagoon (Northern Adriatic Sea). Estuar. Coast. Shelf Sci. 2012, 113, 7–19. [Google Scholar] [CrossRef]
- UNEP, Global Mercury Assessment, Sources, Emissions, Releases and Environmental Transport. UNEP Chemicals Branch 2013, Geneva, Switzerland.
- Chen, J.; McIlroy, S.E.; Archana, A.; Baker, D.M.; Panagiotou, G. A Pollution Gradient Contributes to the Taxonomic, Functional, and Resistome Diversity of Microbial Communities in Marine Sediments. Microbiome 2019, 7, 104. [Google Scholar] [CrossRef]
- Jroundi, F.; Martinez-Ruiz, F.; Merroun, M.L.; Gonzalez-Muñoz, M.T. Exploring Bacterial Community Composition in Mediterranean Deep-Sea Sediments and Their Role in Heavy Metal Accumulation. Sci. Total Environ. 2020, 712, 135660. [Google Scholar] [CrossRef]
- Zhu, H.-S.; Liang, X.; Liu, J.-C.; Zhong, H.-Y.; Yang, Y.-H.; Guan, W.-P.; Du, Z.-J.; Ye, M.-Q. Antibiotic and Heavy Metal Co-Resistant Strain Isolated from Enrichment Culture of Marine Sediments, with Potential for Environmental Bioremediation Applications. Antibiotics 2023, 12, 1379. [Google Scholar] [CrossRef] [PubMed]
- Navarro-Torre, S.; Carro, L.; Igual, J.M.; Montero-Calasanz, M.D.C. Rossellomorea Arthrocnemi Sp. Nov., a Novel Plant Growth-Promoting Bacterium Used in Heavy Metal Polluted Soils as a Phytoremediation Tool. Int. J. Syst. Evol. Microbiol. 2021, 71, 005015. [Google Scholar] [CrossRef]
- Green-Ruiz, C.; Rodriguez-Tirado, V.; Gomez-Gil, B. Cadmium and Zinc Removal from Aqueous Solutions by Bacillus Jeotgali: pH, Salinity and Temperature Effects. Bioresour. Technol. 2008, 99, 3864–3870. [Google Scholar] [CrossRef] [PubMed]
- Tarasov, K.; Yakhnenko, A.; Zarubin, M.; Gangapshev, A.; Potekhina, N.V.; Avtukh, A.N.; Kravchenko, E. Cytobacillus Pseudoceanisediminis Sp. Nov., A Novel Facultative Methylotrophic Bacterium with High Heavy Metal Resistance Isolated from the Deep Underground Saline Spring. Curr. Microbiol. 2023, 80, 31. [Google Scholar] [CrossRef]
- Domingues, V.S.; De Souza Monteiro, A.; Júlio, A.D.L.; Queiroz, A.L.L.; Dos Santos, V.L. Diversity of Metal-Resistant and Tensoactive-Producing Culturable Heterotrophic Bacteria Isolated from a Copper Mine in Brazilian Amazonia. Sci. Rep. 2020, 10, 6171. [Google Scholar] [CrossRef]
- Zampieri, B.D.B.; Pinto, A.B.; Schultz, L.; De Oliveira, M.A.; De Oliveira, A.J.F.C. Diversity and Distribution of Heavy Metal-Resistant Bacteria in Polluted Sediments of the Araça Bay, São Sebastião (SP), and the Relationship Between Heavy Metals and Organic Matter Concentrations. Microb. Ecol. 2016, 72, 582–594. [Google Scholar] [CrossRef]
- Gadhvi, M.S.; Javia, B.M.; Vyas, S.J.; Patel, R.; Dudhagara, D.R. Bhargavaea Beijingensis a Promising Tool for Bio-Cementation, Soil Improvement, and Mercury Removal. Sci. Rep. 2024, 14, 23976. [Google Scholar] [CrossRef]
- Seethalakshmi, P.S.; Prabhakaran, A.; Kiran, G.S.; Selvin, J. Genomic Insights into Plasmid-Mediated Antimicrobial Resistance in the Bacterium Bhargavaea Beijingensis Strain PS04. Arch. Microbiol. 2024, 206, 33. [Google Scholar] [CrossRef]
- Chen, C.; Li, X.; Liang, J.; Yang, X.; Hu, Z.; Li, J.; Xue, Y. The Role of Lysinibacillus Fusiformis S01 in Cadmium Removal from Water and Immobilization in Soil. J. Hazard. Mater. 2025, 485, 136828. [Google Scholar] [CrossRef]
- He, M.; Li, X.; Liu, H.; Miller, S.J.; Wang, G.; Rensing, C. Characterization and Genomic Analysis of a Highly Chromate Resistant and Reducing Bacterial Strain Lysinibacillus Fusiformis ZC1. J. Hazard. Mater. 2011, 185, 682–688. [Google Scholar] [CrossRef]
- Peña-Montenegro, T.D.; Dussán, J. Genome Sequence and Description of the Heavy Metal Tolerant Bacterium Lysinibacillus Sphaericus Strain OT4b.31. Stand. Genomic Sci. 2013, 9, 42–56. [Google Scholar] [CrossRef] [PubMed]
- Golysheva, A.A.; Litvinenko, L.V.; Ivshina, I.B. Diversity of Mercury-Tolerant Microorganisms. Microorganisms 2025, 13, 1350. [Google Scholar] [CrossRef] [PubMed]
- Han, G.; Cooney, J.J. Effects of Butyltins and Inorganic Tin on Chemotaxis of Aquatic Bacteria. J. Ind. Microbiol. 1995, 14, 293–299. [Google Scholar] [CrossRef]
- Pereira-García, C.; Del Amo, E.H.; Vigués, N.; Rey-Velasco, X.; Rincón-Tomás, B.; Pérez-Cruz, C.; Sanz-Sáez, I.; Hu, H.; Bertilsson, S.; Pannier, A.; Soltmann, U.; Sánchez, P.; Acinas, S.G.; Bravo, A.G.; Alonso-Sáez, L.; Sánchez, O. Unmasking the Physiology of Mercury Detoxifying Bacteria from Polluted Sediments. J. Hazard. Mater. 2024, 467, 133685. [Google Scholar] [CrossRef] [PubMed]
- Yi, J.; Lo, L.S.H.; Liu, H.; Qian, P.-Y.; Cheng, J. Study of Heavy Metals and Microbial Communities in Contaminated Sediments Along an Urban Estuary. Front. Mar. Sci. 2021, 8, 741912. [Google Scholar] [CrossRef]

| Distribution (%) of bacterial isolates based on MTC values | |||||||
| metal | 50 mg/L | 100 mg/L | 500 mg/L | 1,000 mg/L | 2,500 mg/L | 5,000 mg/L | >5,000 mg/L |
| Zn | 0 | 1.3% | 52.7%* | 23.0% | 17.6% | 1.4% | 5.4% |
| Cr | 0 | 0 | 29.7% | 18.9% | 10.8% | 9.5% | 31.1% |
| Cd | 5.4% | 4.1% | 70.3% | 14.9% | 1.4% | 2.7% | 1.4% |
| Hg | 90.5% | 6.8% | 2.7% | 0 | 0 | 0 | 0 |
| Distribution (%) of bacterial isolates based on MTC values | |||||||
| metal | 100 mg/L |
500 mg/L |
1,000 mg/L | 2,500 mg/L | 5,000 mg/L | 10,000 mg/L | >10,000 mg/L |
| Sn | 25.7% | 28.4% * | 12.2% | 10.8% | 8.1% | 5.4% | 9.5% |
| Pb** | 1.4% | 0 | 1.4% | 5.5% | 8.2% | 8.2% | 75.3% |
| Cu | 1.4% | 27.0% | 16.2% | 24.3% | 21.6% | 5.4% | 4.1% |
| Co | 0 | 0 | 1.4% | 18.9% | 37.8% | 27% | 14.9% |
| Ni | 0 | 0 | 1.4% | 9.5% | 33.8% | 35.1% | 20.3% |
Disclaimer/Publisher’s Note: The statements, opinions and data contained in all publications are solely those of the individual author(s) and contributor(s) and not of MDPI and/or the editor(s). MDPI and/or the editor(s) disclaim responsibility for any injury to people or property resulting from any ideas, methods, instructions or products referred to in the content. |
© 2025 by the authors. Licensee MDPI, Basel, Switzerland. This article is an open access article distributed under the terms and conditions of the Creative Commons Attribution (CC BY) license (http://creativecommons.org/licenses/by/4.0/).





